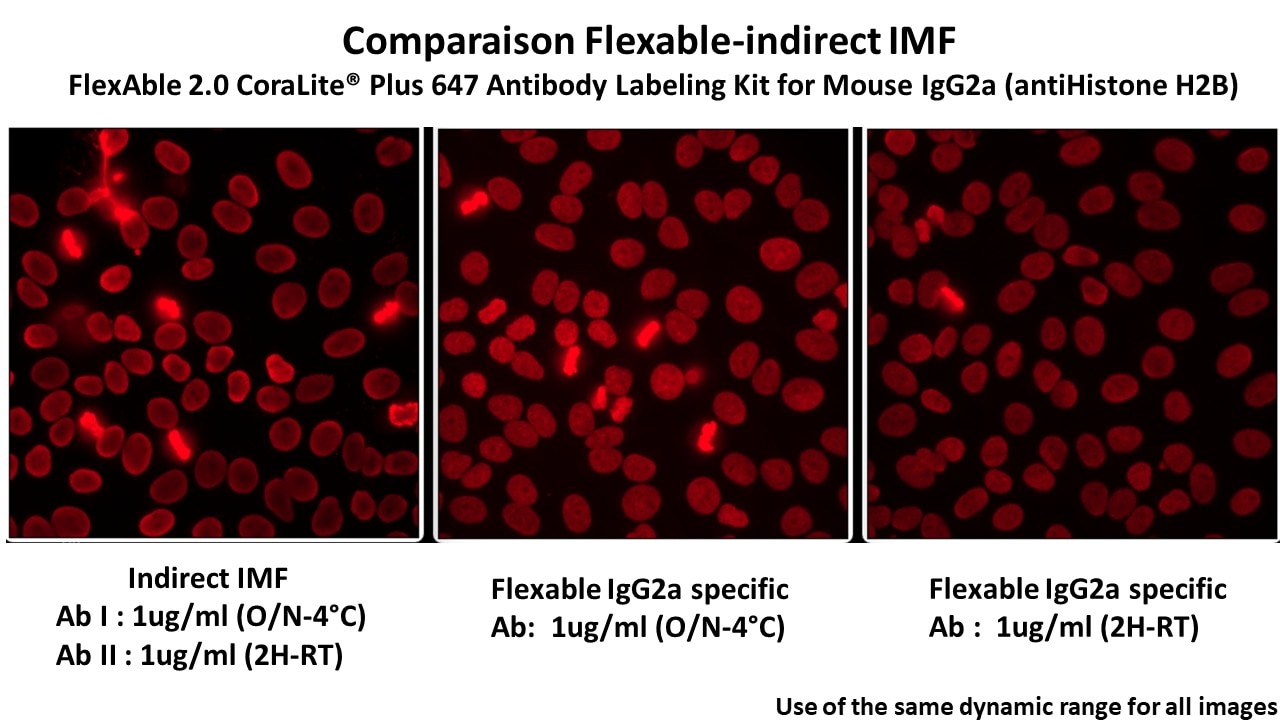

Product Information
| Product name | FlexAble 2.0 CoraLite® Plus 647 Antibody Labeling Kit for Mouse IgG2a |
| Assay type | Antibody labeling |
| Tested applications | IF, FC, WB |
| Species Reactivity | Mouse IgG2a |
| Antibody amount per labeling reaction | 0.5 µg antibody |
| Conjugate | CoraLite® Plus 647 |
| Excitation/Emission maxima wavelengths | 654 nm / 674 nm |
Kit Components
| Component | 10rxns | 50rxns | 200rxns |
|---|---|---|---|
| FlexBuffer | 100ul | 500ul | 2000ul |
| FlexLinker 2.0 CoraLite® Plus 647 for Mouse IgG2a | 10ul | 50ul | 200ul |
| FlexQuencher for Mouse IgG2a | 20ul | 100ul | 400ul |
Ship Condition
shipped on blue iceStorage Condition
Store for 1 year at -20°C or for 6 months at +4°C upon receipt. Avoid exposure to lightFAQ
Q: What is the difference between FlexAble and FlexAble 2.0 products?
A: FlexAble 2.0 has been improved to allow for more dyes per FlexLinker than the previous version of the kit. This results in an increased signal per antibody.
Q: What are the FlexLinker, FlexQuencher and FlexBuffer?
A: The FlexLinker is a small polypeptide to which dyes are covalently conjugated that can label unconjugated primary antibodies. The FlexQuencher is an Fc-containing fragment that neutralizes the excess FlexLinker. The FlexBuffer is a PBS-based buffer.
Q: What is the largest quantity I can label?
A: With a standard kit size (50 reactions), you can label 25 µg of one antibody or up to 50 different antibodies. You can easily scale up the antibody amount per labeling approach.
Q: What is the lowest concentration of my primary antibody that I can use?
A: Our protocol uses 0.5 µg of primary antibody in 7 µL, which ends up at 0.07 mg/mL. If the concentration of your antibody is lower, you can also use a larger volume than 7 µL.
Q: Can I label primary antibodies stored in BSA, glycerol, Tris buffer and/or preservatives?
A: Yes, FlexAble Antibody Labeling Kits have been validated with carriers and amine buffers. Neither BSA nor amine buffers, in any chosen concentration, interfere with the labeling. 50% glycerol as well as preservatives like sodium azide are also compatible with the kit.
Q: How many different primary antibodies can I label with one kit?
A: You can label up to 50 different antibodies with our FlexAble 50 rxn Kit, and up to 10 antibodies with our FlexAble 10 rxn Kit.
Q: Will I observe cross-reactivity/leaking when I use two FlexAble-labeled antibodies from the same species during multiplexing?
A: FlexAble labels primary antibodies with a high affinity FlexLinker. Dissociation of FlexLinker from one antibody and association to another antibody is rare. If you observe leaking, we recommend adding more FlexQuencher to remove unbound FlexLinker, or you can try sequential staining of the labeled antibodies.
Documentation
| SDS |
|---|
| KFA543-SDS-FlexAble 2.0 CoraLite Plus 647 Antibody Labeling Kit |
| Protocol |
|---|
| Protocol-FlexAble and FlexAble 2.0 Antibody Labeling Kits |
| Customer testimonials |
|---|
| Léa Pechtimaldjian on Advancing 3D Vascular Imaging with FlexAble Technology |
| White papers |
|---|
| Efficient Hybridoma Screening with FlexAble Antibody Labeling Kits |
Publications
| Application | Title |
|---|---|
J Immunother Cancer Novel antibodies for identification, selection, and manipulation of T cells expressing Whitlow linker-containing CARs |
Reviews
The reviews below have been submitted by verified Proteintech customers who received an incentive for providing their feedback.
FH Yves (Verified Customer) (09-11-2025) | Flex Linker LM0000394/Flex Quencher D0000137/Flex Buffer2859564
![]() |